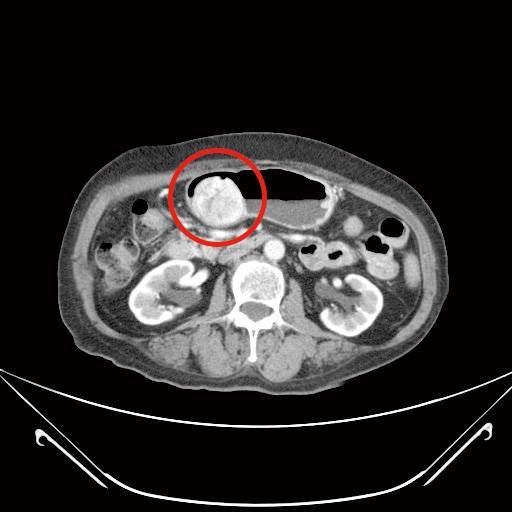
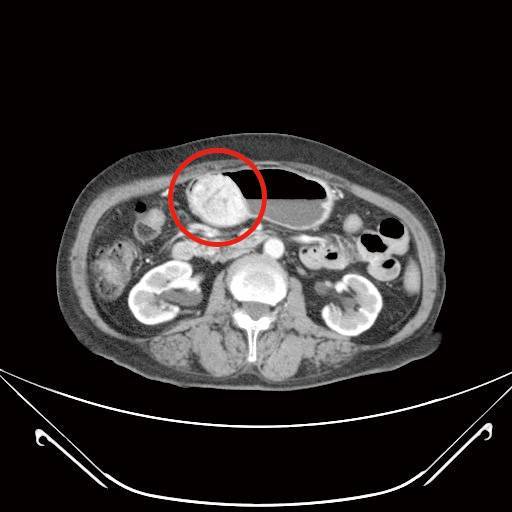
微創手術根除胃腸道基質瘤合併膽結石

國泰醫院一般外科主治醫師 蔡欣恬
72歲林女士,3年前經上消化道內視鏡檢查發現有個2公分大的胃黏膜下腫瘤,疑似胃腸道基質瘤,持續門診追蹤,近期發現腫瘤緩慢長大,2個月前因上腹部悶痛且頭暈就診,由於合併有血便症狀,經上消化道內視鏡及電腦斷層檢查,發現腫瘤已接近6公分,且膽囊被結石塞滿,沒有膽汁的空間,經過和病人及家屬充分討論,醫療團隊以達文西系統機器手臂輔助腹腔鏡手術,為病人進行部分胃切除以及膽囊切除手術,手術順利,病人於術後第9天出院。病理化驗報告證實胃部腫瘤屬於低度分化惡性胃腸道基質瘤,評估後僅需定期追蹤檢查,膽囊則是慢性膽炎。
胃腸道基質瘤(上圖)

膽囊炎(上圖)
胃腸道基質瘤(GIST),是由腸胃道肌肉層的間質細胞長出來的惡性腫瘤,佔所有腸胃道癌症的2%左右,好發於年長病人,且年齡約在65-69歲,但也有不到2%的機率發生在20歲以下年輕病人(多與基因遺傳有關)。據跨國統計顯示,在香港、台灣、韓國與挪威有較高的發生率,約每百萬人有19-22人,美國及加拿大的發生率約每百萬人有7-8人。
胃腸道基質瘤在腫瘤還小時,鮮少有症狀,通常有症狀時多已大於2公分,由於臨床症狀沒有特異性,常見如腹部脹悶不適、噁心嘔吐、大便出血、體重減輕及排便習慣改變等,依照腫瘤生長位置不同而有不同的臨床表現。
目前針對胃腸道基質瘤主要的治療方式以手術切除為主,標靶治療為輔。若是經過評估已經有遠端轉移,或腫瘤原發位置屬於手術高度危險區域,或腫瘤太大而無法一次手術完整切除,這些狀況可以先給予標靶治療,這種前導性治療的模式有機會將無法手術的病況轉變成可以手術,而達到更好的治療效果。也因為標靶藥物的介入,整體平均存活率增加3成以上。
手術的目標在於完整將腫瘤切除,以往這類患者需接受超過15公分傷口的剖腹手術(傷口位於腹部正中間),考量病人合併有膽結石問題,故建議接受達文西微創手術,做更細緻的剝離及切除,也可同時處理胃部惡性腫瘤及膽結石,由於術後僅1個3-5公分及3-4個1公分傷口,大幅降低病人術後傷口疼痛感,有助盡早恢復體力與活動力,更快回到日常生活。
目前衞生福利部對於多項達文西手術已提供手術的健保給付,以一般外科而言,舉凡肝膽胰手術、腸胃道手術(包含減重手術)、疝氣手術,都有健保補助,病人僅需自費相關醫材。
由於胃腸道基質瘤早期幾乎沒有症狀,症狀的臨床表現也無特異性,因此很容易被忽略,特別提醒年長者如有腹部脹悶不適、噁心嘔吐、大便出血等症狀,務必多留意,必要時進一步就醫確認。